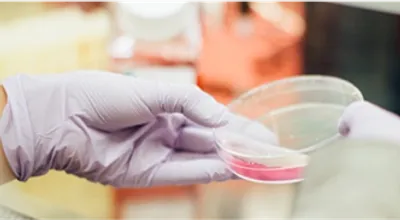
Medical-Support-Access

Exclusive Tour Services
Book exclusive private tours with NCG Experience. Our expert guides provide access to restricted sites and hidden places that most travelers never see.

Our Exclusive Tour Services Include
Custom Itinerary Creation

Interest-Based Design
We design tours based on your interests and time

Hidden Gem Access
We include off-path locations not in guidebooks

Balanced Experiences
We balance famous sites with hidden places

Pacing Adjustment
We adjust pacing to match your energy level
Expert Guide Selection

Regional Expertise Matching
We match you with guides who know specific regions

Interest-Specific Knowledge
We find guides with knowledge in your interest areas

Language Compatibility
We select guides who speak your preferred language

Proven Service
We use only guides with proven service records
Private Access Arrangements

Restricted Venue Entry
We secure entry to restricted or closed venues

Off-Hours Visits
We arrange visits outside regular opening hours

Permit Acquisition
We obtain permits for limited-access natural areas

Local Expert Connections
We connect you with local experts and artisans
Complete Logistics Management

Site Transportation
We handle all transportation between sites

Local Dining Setup
We arrange meals at local favorites

Weather Backup Plans
We prepare backup plans for weather issues

On-the-Fly Adjustments
We adjust tours as needed during your trip

Why Choose NCG Why Choose NCG Experience for Exclusive Tours
Local Connections

Site Relationship Network
We maintain relationships with site managers and owners

Special Access Contacts
We know who can grant special access in each region

Community Partnerships
We work with community leaders in remote areas

Local Business Support
We support local guides and businesses
Genuine Experiences

Authentic Cultural Exchange
We focus on real cultural exchanges

Tourist Trap Avoidance
We avoid tourist traps and staged demonstrations

Local Resident Meetings
Local-Resident-Meetings

Real Food & Crafts
We find authentic food and craft experiences
Comfort and Safety

Location Safety Monitoring
Location Safety Monitoring

Comfortable Transportation
We provide comfortable transport between sites

Food Quality Checks
We check food safety and quality in advance
Medical Support Access
We arrange medical support when needed
Total Flexibility

Interest-Based Adjustments
We adjust tours based on your changing interests

Extended Enjoyment Stops
We extend visits at places you enjoy most

Dynamic Itinerary Updates
We add or remove stops based on your feedback

Flexible Daily Scheduling
We start and end each day on your schedule

Our Tour Categories
We offer different types of exclusive tours to match your interests:
Cultural Immersion
Deep connections with local communities

Historical Access
Private entry to important historical sites

Natural Wonders
Guided access to protected natural areas

Food and Craft
Personal meetings with top chefs and artisans
Travel Reviews
"Our NCG guide in Kyoto took us to a private tea ceremony in a temple closed to the public. It became the highlight of our Japan trip."
Robert F., Business Owner
"The private tour NCG arranged in Egypt included after-hours access to tombs that are normally restricted. Our guide was a respected Egyptologist."
Jennifer M., Professor
"We wanted to see the real Bali, not just tourist spots. Our NCG guide introduced us to village leaders and artists we would never have met on our own."
David and Sarah K., Retired Couple
Inquire Now
It’s essential to provide more specific information about your travel plans and needs. Traveling with NCG always requires a personalized approach to tailor recommendations to your preferences and requirements.
Common Questions About Exclusive Tours
How are exclusive tours different from regular tours?
Exclusive tours provide private guides, avoid crowds, include special access to restricted sites, and can be fully customized to your interests.
How long are typical exclusive tours?
We can arrange tours from half-day experiences to multi-week journeys. Most clients prefer 1-2 week tours with daily guided activities.
Can you arrange tours in remote or difficult locations?
Yes. We specialize in creating tours in places that are hard to access. We handle all permits, transportation, and local arrangements.
Do guides stay with us the entire time?
This depends on your preference. We can arrange full-time guides or schedule guided time with free time for independent exploration.